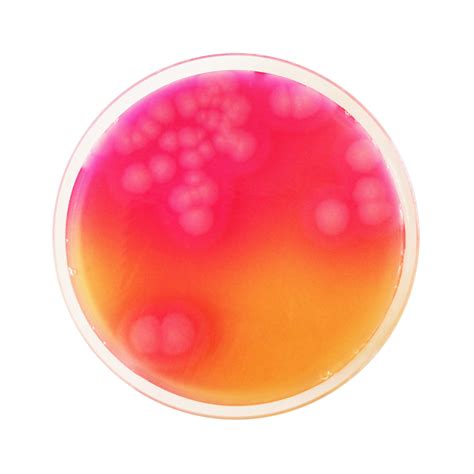
Ilustración de colonias de Bacillus cereus con halo de precipitación en agar MYP.

La correcta preparación de los medios de cultivo es fundamental en cualquier laboratorio microbiológico. Si tus medios "no salen igual" entre lotes o el pH deriva tras la esterilización, es probable que se deba a la falta de un protocolo estandarizado. La implementación adecuada de estos protocolos, de acuerdo con estándares internacionales, garantiza la reproducibilidad, trazabilidad y conformidad regulatoria en cualquier tipo de medio de cultivo.
El protocolo universal de preparación de agar según estándares como la ISO 11133:2014 es la base fundamental para asegurar la calidad en el laboratorio.
¿Qué es el Agar MYP (Manitol Yema de Huevo Polimixina)?
El agar Manitol Yema de Huevo Polimixina (MYP) es un medio de cultivo selectivo y diferencial utilizado principalmente para el recuento y la identificación presuntiva de Bacillus cereus. Este medio es esencial en el análisis microbiológico de alimentos, piensos animales, muestras ambientales y otros materiales, debido a la importancia de B. cereus como patógeno transmitido por alimentos.

Composición y Mecanismo de Detección del Agar MYP
El agar MYP base contiene una combinación de ingredientes que permiten la identificación diferencial de Bacillus cereus:
- Digestión enzimática de caseína y extracto de carne: Proporcionan las fuentes de carbono y nitrógeno necesarias para el crecimiento bacteriano.
- Manitol: Es un alcohol de azúcar que actúa como hidrato de carbono fermentable.
- Rojo fenol: Es un indicador de pH que cambia de color según la producción de ácidos a partir de la fermentación del manitol.
- Yema de huevo: Componente crucial para la detección de la actividad lecitinasa.
- Polimixina: Es un componente inhibidor selectivo que suprime el crecimiento de muchos microorganismos no deseados.
Diferenciación de Bacillus cereus
El medio MYP utiliza dos sistemas indicadores clave para la diferenciación:
- Fermentación de manitol: Las bacterias que fermentan manitol para producir ácidos causan una coloración amarilla del medio, debido al indicador rojo fenol. Bacillus cereus no fermenta manitol, por lo que el medio alrededor de las colonias permanece sin cambios o se decolora ligeramente debido a una ligera alcalinización, formando colonias rosadas.
- Actividad lecitinasa: La lecitina presente en la yema de huevo es escindida por la lecitinasa de Bacillus cereus. Esto conduce a la formación de una zona de precipitación opalescente blanca que rodea las colonias rosadas.
Es importante tener en cuenta que algunas especies de Bacillus como Bacillus anthracis, Bacillus mycoides, Bacillus pseudodomycoides, Bacillus thuringiensis y Bacillus weihenstephanensis pueden no ser distinguibles de Bacillus cereus en este medio.
Preparación y Parámetros del Agar MYP
Para la preparación de agar MYP, se utilizan formulaciones comerciales que suelen requerir la adición de suplementos selectivos (como Polimixina B) y emulsión de yema de huevo para potenciar la selectividad y las condiciones de crecimiento. Un pH de 7.0 a 7.4 (a 25 °C, con 43 g/L en H2O, después de la esterilización en autoclave) es el rango óptimo para este medio.
El seguimiento de guías como las de la Organización Internacional de Normalización (ISO) es crucial para asegurar la calidad.
Control de Calidad del Agar MYP
El control de calidad es un paso indispensable para asegurar el rendimiento del agar MYP. Las pruebas de promoción de crecimiento se realizan de acuerdo con la versión actual de la norma DIN EN ISO 11133.
Resultados Típicos de la Prueba de Promoción de Crecimiento:
- Inóculo en medio de referencia (Bacillus cereus ATCC 11778 (WDCM 00001)): Recuento de colonias (Bacillus cereus ATCC 11778 (WDCM 00001)): Recuperación en medio de prueba (Bacillus cereus ATCC 11778 (WDCM 00001)): ≥ 50%. Una tasa de recuperación del 50% es equivalente a un valor de productividad de 0.5.
- Crecimiento (Bacillus subtilis ATCC 6633 (WDCM 00003)): Sin límite.
- Crecimiento (Escherichia coli ATCC 8739 (WDCM 00012)): Inhibición total.
- Crecimiento (Escherichia coli ATCC 25922 (WDCM 00013)): Inhibición total.
Apariencia de las Colonias:
- Colonias (Bacillus cereus ATCC 11778 (WDCM 00001)): Colonias rosadas con halo de precipitación.
- Colonias (Bacillus subtilis ATCC 6633 (WDCM 00003)): Colonias amarillas sin halo de precipitación.
Condiciones de Incubación:
- B. cereus: 24 ± 3 a 44 ± 4 horas a 30 ± 1 °C.
- Otras cepas de prueba: 44 ± 4 horas a 30 ± 1 °C.
AGAR MacCONKEY MICROBIOLOGÍA l AGAR MacCONKEY ESPAÑOL l MacConkey Agar 2021
Estándares y Documentos Clave para la Calidad de Medios
La adherencia a los estándares internacionales es vital para asegurar la calidad y validez de los resultados en la preparación de medios de cultivo. Algunos documentos clave incluyen:
- International Organization for Standardization (2014). Microbiology of the food chain - Preparation and production of culture media - General guidance on quality assurance for preparation of culture media in the laboratory (ISO 11133:2014).
- ASTM International (2021). Standard test method for gel strength of agar (ASTM D1084-21).
- Clinical and Laboratory Standards Institute (2019). Quality assurance for commercially prepared microbiological culture media (M22-A3). CLSI.
- United States Pharmacopeial Convention (2021). Microbiological media preparation and quality control. In United States Pharmacopeia (USP 44-NF 39, pp. 1823-1865). USP.
- Bridson, E. Y. (2022). The Oxoid manual of culture media, ingredients and other laboratory services (10th ed.). Thermo Fisher Scientific.
- Sutton, S., & Cundell, T. (2023). Microbial culture media: Formulation, preparation, and quality control considerations. Pharmaceutical Technology, 47(8), 32-38.
- Williams, R. P., & Johnson, M. K. (2024). Automated culture media preparation: Impact on laboratory efficiency and quality assurance. Laboratory Medicine, 55(3), 156-164.